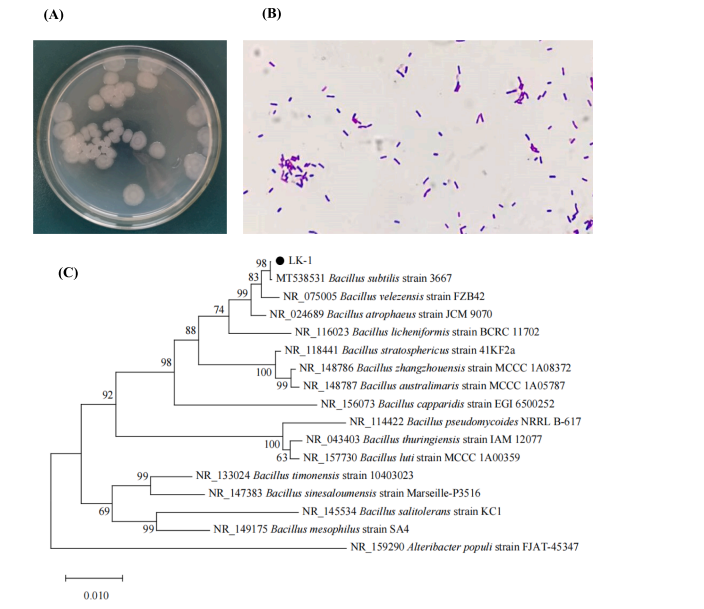
富硒茶抗氧化活性成分(抗氧化活性成分有哪些)-硒宝网

富硒茶抗氧化活性成分(抗氧化活性成分有哪些)
黑茶 2024


DOI: 10.1016/j.fochx.2023.100811

枯草芽孢杆菌LK-1固态发酵对
黑茶挥发性成分、儿茶素组成
及抗氧化活性的影响

茯砖茶(FBT)是一种传统的微生物后发酵黑茶,具有多种生物活性物质而有益于健康的特点。早期研究表明,芽孢杆菌物种有助于茶叶香气特征的形成且枯草芽孢杆菌发酵对茶叶品质有显著影响。因此,芽孢杆菌在FBT生产过程中对代谢物的形成起着至关重要的作用。
据此,本团队成员杨成洪旺和肖磊柯等利用FBT生产微生物发酵过程中分离得到的枯草芽孢杆菌LK-1对黑茶进行固态发酵(SSF),研究发酵过程中挥发性有机化合物、非挥发性成分和抗氧化活性的动态变化以阐明枯草芽孢杆菌在FBT代谢产物形成中的作用,为理解黑茶发酵过程中细菌参与形成独特的挥发性物质和非挥发性代谢产物提供理论支持。
01
菌株鉴定

LK-1菌株菌落形态呈灰色,近似圆形,不透明,表面略扁平,边缘呈锯齿状,可以看到清晰的同心圆环的形状。菌株革兰氏染色结果为阳性,显微镜下,菌株呈棒状形态,末端钝而圆,细胞没有明显肿胀。在生理生化特征符合枯草芽孢杆菌鉴定标准的基础上进一步对LK-1菌株16S rDNA基因进行测序,并将其与NCBI GenBank数据库中的序列进行比较。结果表明,LK-1菌种16S rDNA基因序列与枯草芽孢杆菌的相似度高达99%,继续利用16条相似性较高的序列构建系统发育树,LK-1菌株与枯草芽孢杆菌聚集在一起,关系密切。因此,LK-1鉴定为枯草芽孢杆菌。
图1. A图是LK-1菌株在LB培养基上接种12 h菌落形态;
B图是LK-1菌株革兰氏染色图;C图是LK-1菌株
16S rDNA的PCR系统发育树图。
02
气相色谱-质谱联用技术对
VOCs进行定性和定量分析

GC-MS共鉴定出45种挥发性有机化合物,包括醛类7种、酯类2种、醇类6种、酮类18种、碳氢化合物8种、杂环类3种和内酯类1种。在相对比例方面,酮类(40%)、碳氢化合物(17.78%)、醛类(15.56%)和醇类(13.33%),占比较大。韦恩图分析每个样本之间的共同的特征和独特的特征,结果表明,各组共有29种挥发性有机化合物,且随着发酵天数的增加,挥发性有机化合物的数量逐渐增加。
在发酵后,酮从3790.40 ng/g增加到6424.52 ng/g,醇的含量从762.57 ng/g增加到3579.28 ng/g。醇类化合物与果香和花香,而酮类化合物与木香和花香有关,这表明枯草芽孢杆菌在黑茶的SSF过程中有助于增强花香和木香。在发酵第8天,VOCs总浓度达到了最高水平。


图2. A图是GC-MS总离子色谱图;B图是是所有VOCs分类图;
C图是韦恩图;D图是不同挥发物含量变化。
03
SSF过程中黑茶的挥发性
有机化合物的变化

采用主成分分析(PCA)和层次聚类分析(HCA)进行数据可视化,结果表明,HCA结果与PCA结果一致。BDT0与BDT6/BDT8的分离最为显著,说明枯草芽孢杆菌对黑茶发酵后期的风味成分有显著的影响,BDT0和BDT2样品相互接近,说明发酵0天和2天的黑茶具有相似的风味成分。
枯草芽孢杆菌发酵黑茶的SSF中,水杨酸甲酯浓度在发酵中期达到最大值,芳樟醇和α-松油醇含量增加,且芳樟醇成为含量最高的化合物。酮类化合物包括:6-甲基-5庚烯-2-酮、α-紫罗兰酮、β-紫罗兰酮、香叶酮和异佛罗酮,所占比例最大,SSF过程后它们的含量显著增加。醛类物质中,苯甲醛是形成茶叶特有香气的关键风味化合物,具有花香的作用,它的甲基衍生物2,2,4-三甲基-3-环己烯-1-甲醛的含量增加,而苯甲醛的含量显著降低。β-环柠檬醛和藏红花醛是黑茶的特征香气成分,发酵后其浓度增加,它们主要通过β-胡萝卜素的氧化和降解产生。


图3. E图是主要成分分析图;F图是系统聚类分析图;G图是不同发酵阶段黑茶挥发性有机化合物信号强度的载荷图;H图是用GC-MS检测枯草芽孢杆菌发酵黑茶过程中所有挥发性有机化合物的热图分析。
04
关键挥发性化合物

通过相对气味活性值(ROAV)分析评估SSF过程中不同挥发物对黑茶香气的贡献。在BDT8中鉴定出7种ROAV>1的关键VOCs: α-紫罗兰酮、藏红花醛、雪松醇、癸醛、3,5-辛二烯-2-酮、β-紫罗兰酮和芳樟醇。
其中芳樟醇的ROAV最高,对黑茶的风味贡献最大,SSF后,其含量增加,使黑茶具有甜而清新的花香,带有佛手柑的清香。β-紫罗兰酮有助于黑茶的花香和紫罗兰香气,α-紫罗兰酮具有紫罗兰和木质的香气,对茶叶香气有显著影响。3,5-辛二烯-2-酮为黑茶提供水果香气,藏红花醛增强了黑茶的花香和果香,雪松醇则有着软雪松和香甜的气味。尽管癸醛的浓度很低,但具有很高的ROAV,并为黑茶带来柑橘和花香的香气。发酵后这些挥发性有机化合物的浓度显著升高,增强了黑茶的花香和果香。


表1. 气相色谱-质谱法测定枯草芽孢杆菌发酵黑茶中挥发性物质的含量。
05
黑茶在固态发酵过程中
主要代谢产物的变化

在枯草芽孢杆菌LK-1固态发酵过程中,总多酚含量在SSF过程中有所下降,而总黄酮含量在发酵中期略有增加,后期又有所下降。研究发现,ABTS自由基清除活性和螯合能力在发酵的早期和中期保持相对稳定,在BDT6阶段保持了大约90.38%和92.07%的原始抗氧化活性,而在BDT8阶段ABTS自由基清除活性显著下降。DPPH自由基清除活性和还原力在整个发酵过程中略有下降,但在BDT8阶段仍保持了大约91.14%和94.78%的原始活性。综上所述,通过枯草芽孢杆菌发酵,保持黑茶最大抗氧化活性和增强黑茶风味的最佳时期为BDT6。


图4. (A)总多酚、(B)总黄酮类化合物的含量。
(C)ABTS自由基清除活性,(D)DPPH自由基清除活性,
(E)还原能力,(F)不同时间枯草杆菌发酵黑茶的螯合能力。
此外,儿茶素是茶多酚的主要组成部分,分为酯类和非酯类两种,对茶叶风味的形成起着关键作用。研究通过高效液相色谱法鉴定和定量分析了发酵过程中BDT样品中儿茶素的含量变化,结果显示酯类儿茶素显著减少,而非酯类儿茶素大幅增加。这些变化可能有助于减轻茶叶的苦涩味和涩感。

表2. GA、没食子酸;GC,没食子儿茶素;EGC,表没食子儿茶素;C,儿茶素;EC、表儿茶素;EGCG,表没食子儿茶素没食子酸酯;GCG,没食子儿茶素没食子酸酯;ECG,表儿茶素没食子酸酯;CG,儿茶素没食子酸酯。每个茶样测定3次重复。字母表示不同样本( p < 0.05)之间的Duncan ' s两两差异。
06
黑茶在固态发酵过程中
抗氧化活性的变化

采用主成分分析( PCA )考察抗氧化活性、生物活性成分和抗氧化能力之间的关系。位于图S1A右上象限的BDT4和BDT6样品与PC1和PC2呈正相关,表明多酚代谢物水平较高,具有较强的抗氧化活性,ABTS、DPPH和CHA在PC1上的负载模式表明它们与抗氧化活性相关。此外,EGCG、ECG、GCG、TPC、CG和EC在PC1上的负载量较高,表明多酚是有效的抗氧化剂。

图S1 不同发酵时间黑茶代谢产物和抗氧化活性
的主成分分析得分(A)和负载图(B)。
通过相关分析验证茶产品的抗氧化活性与茶多酚之间的关系,值得注意的是,EGCG、GCG、ECG和DPPH之间存在显著的正相关关系。同样,GCG、ECG和RP也表现出显著的正相关性。O -二羟基或三羟基结构能够螯合金属离子并抑制自由基的产生,是儿茶素具有强抗氧化活性的化学结构之一。其中,表没食子儿茶素没食子酸酯( EGCG )以其4个二羟基被公认为最有效的茶叶抗氧化剂。尽管EGCG和其他酯型儿茶素的含量大幅下降,但黑茶仍然保持了较高的抗氧化活性。这可归因于EGCG降解为EGC,EGC在B环上具有高度的羟基化,从而产生极大的抗氧化能力。此外,EGCG的降解产物可能与其他成分(如抗坏血酸、维生素E等)产生协同作用,进一步增强抗氧化能力。


图5. (A)枯草芽孢杆菌固态发酵过程中挥发性有机物
与主要非挥发性代谢物的相关性分析(B)枯草杆菌发酵黑茶
的抗氧化活性与儿茶素、总酚、总黄酮含量的相关性。
结 论

本研究探索了枯草芽孢杆菌LK-1对黑茶挥发物质、儿茶素组成和抗氧化活性的影响。研究发现,经过固态发酵后,黑茶中的挥发性有机化合物发生了显著变化,其中芳香醇、β-离子酮和3,5-辛二烯-2-酮等关键气味活性物质的含量显著增加,使得茶叶的花香和果香更加丰富。此外,酯类儿茶素显著减少,而非酯类儿茶素显著增加,这种成分的变化可能有助于减轻茶叶的苦涩味和涩感??寡趸钚杂隕GCG、GCG和ECG的含量呈正相关,并且在发酵的第六天保持较高水平。这表明,使用枯草芽孢杆菌进行为期6天的发酵是保持黑茶高抗氧化活性和增强黑茶风味的最佳时期。这些发现为未来研究提供了有价值的基础,有助于深入探讨细菌对发酵黑茶品质形成的影响。
第一作者简介

肖磊柯,女,湖南农业大学食品科学技术学院20级本科生,专业食品科学与工程,研究方向食品微生物,导师肖愈。

杨成洪旺,男,湖南农业大学食品科学技术学院22级研究生,专业食品加工与安全,研究方向为食品微生物,导师肖愈。
通讯作者简介

肖 愈,博士/博士后,湖南农业大学硕士研究生导师。2018年博士毕业于南京农业大学食品科学与工程专业,2016-2017年曾受国家留学基金委公派在美国新泽西州立罗格斯大学Chi-Tang Ho教授课题组进行博士联合培养,湖南农业大学园艺学院茶学专业博士后。主要研究方向为传统发酵食品微生物资源的发掘与应用、黑茶加工品质化学、功能性食品的研究与开发。目前已发表学术论文50余篇,其中以第一作者或通讯作者在Food Chemistry、Food Research International、LWT-Food Science and Technology、Journal of Functional Foods、Innovative Food Science & Emerging Technologies等期刊上发表SCI论文20余篇,其中JCR一区16篇,参编教材2部。主持了湖南省自然科学基金、湖南省优秀博士后创新人才项目、湖南省教育厅优秀青年项目、湖南省科技特派员服务乡村振兴项目、湖南农业大学神农学者II层次引进人才项目及参与了国家自然科学基金等项目的研究。获得湖南省微生物学会“十佳青年科技奖”及1项湖南省科技进步二等奖。担任过Frontiers in Nutrition (JCR Q1,影响因子6.590)及Agronomy (JCR Q1,影响因子3.949)等SCI期刊的客座编辑,Beverage Plant Research期刊青年编委,以及担任Food Chemistry、Journal of Agricultural and Food Chemistry、 Food Research International、LWT- Food Science and Technology、Journal of Functional Foods、Food & Function等30余个国际知名SCI期刊的审稿人。


/文章获取/
Citation:Leike Xiao, Chenghongwang Yang, Xilu Zhang, Yuanliang Wang, Zongjun Li, Yulian Chen, Zhonghua Liu, Mingzhi Zhu, Yu Xiao.Effects of solid-state fermentation with Bacillus subtilis LK-1 on the volatile profile, catechins composition and antioxidant activity of dark teas.Food Chemistry: X,Volume 19,
2023,100811,ISSN 2590-1575.
DOI:
